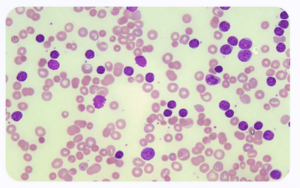

1. Introducción a la leucemia linfocítica aguda
La leucemia linfocítica aguda (LLA) representa una de las neoplasias malignas más desafiantes en la hematología pediátrica y de adultos. Se caracteriza por la proliferación descontrolada de linfocitos inmaduros, conocidos como blastos, que se acumulan en la médula ósea e interfieren en la producción normal de células sanguíneas.
El diagnóstico temprano y preciso es vital para el manejo efectivo de la LLA. Los especialistas emplean un enfoque multidisciplinario que incluye análisis citogenéticos, estudios de inmunofenotipo y la realización de pruebas moleculares para clasificar los subtipos de LLA, lo que es crucial para establecer la estrategia terapéutica más adecuada para cada paciente.
El tratamiento ha avanzado significativamente en las últimas décadas, mejorando las tasas de supervivencia. La terapia está compuesta por quimioterapia, terapia dirigida y, en ciertos casos, el trasplante de células progenitoras hematopoyéticas. Sin embargo, el manejo de efectos secundarios y la prevención de recaídas son áreas que continúan representando un reto considerable para el equipo de salud en cuestión.


2. Definición y clasificación de la leucemia linfocítica aguda
La leucemia linfocítica aguda (LLA) es una neoplasia maligna caracterizada por la producción descontrolada de linfocitos inmaduros, denominados blastos. Estos linfocitos se acumulan en la médula ósea, interfiriendo en la producción normal de células sanguíneas. La LLA se clasifica principalmente por su origen en dos grandes tipos: de células B y de células T, cada una con características clínicas y pronósticas distintas.
La epidemiología de la LLA muestra una mayor incidencia en la infancia, disminuyendo su prevalencia con la edad adulta. A pesar de esto, la complejidad del tratamiento y el manejo en adultos resulta en un desafío particular para los especialistas.
La LLA de células B representa aproximadamente el 85% de los casos y suele tener un mejor pronóstico comparada con la de células T. Los blastos de células B suelen presentar un fenotipo precursor B, con positividad para CD10, CD19 y CD22. La translocación cromosómica t(9;22), conocida como cromosoma Filadelfia, es uno de los marcadores genéticos más relevantes en este subtipo.
Por otro lado, la LLA de células T, que abarca el 15% restante de los casos, puede presentarse con una masa mediastínica y es más común en adolescentes y adultos jóvenes. Los marcadores inmunofenotípicos incluyen la expresión de antígenos como CD2, CD3, CD7 y CD8.
El pronóstico de la LLA se ve afectado por una serie de factores biológicos y clínicos. Entre ellos, la edad del paciente, la carga de la enfermedad al diagnóstico y la respuesta al tratamiento son decisivos. Además, las alteraciones cromosómicas y genéticas como la hiperdiploidía o la presencia de fusiones génicas específicas como TEL-AML1 confieren diferente respuesta al tratamiento y sobrevida.
La LLA es clasificada en grupos de riesgo (bajo, intermedio y alto riesgo) según criterios establecidos que incluyen, pero no se limitan a, el recuento de leucocitos al diagnóstico, la edad del paciente, el subtipo inmunofenotípico y las características genéticas. Estas clasificaciones son esenciales para definir las estrategias de tratamiento individualizadas y mejorar las tasas de curación.

3. Epidemiología de la leucemia linfocítica aguda
La leucemia linfocítica aguda (LLA) representa el tipo más común de leucemia en la infancia, aunque afecta también a adultos con una incidencia que aumenta con la edad. Su epidemiología refleja una distribución que varía sustancialmente con la edad, el género y la etnicidad.
Incidencia y prevalencia: La LLA tiene una mayor incidencia en niños pequeños, especialmente entre los 2 y 5 años. A nivel mundial, los estudios reflejan una prevalencia significativa en la población pediátrica, siendo menos común en adultos.
Distribución por género: Existe una leve predisposición masculina en la incidencia de la LLA, especialmente en la población pediátrica.
Variaciones étnicas: Los estudios demuestran que hay diferencias en la incidencia de LLA entre diferentes grupos étnicos, siendo más alta en poblaciones caucásicas y hispanas en comparación con asiáticos y afroamericanos.
Factores de riesgo genéticos: Anomalías cromosómicas como la translocación t(12;21)(p13;q22) o la hiperdiploidía se asocian con un mayor riesgo de desarrollar LLA. Además, se debe tener en cuenta el historial familiar y síndromes genéticos preexistentes.
Influencia del entorno y exposiciones: Si bien no se ha establecido un vínculo directo y claro, se discuten factores como exposiciones químicas, radiaciones ionizantes y ciertos patrones infecciosos como posibles contribuyentes al desarrollo de la LLA.
Entender la epidemiología de la LLA es crucial para desarrollar estrategias efectivas de prevención y tratamiento. A pesar de los avances en medicina, continúa siendo un reto establecer correlaciones concretas entre factores ambientales y genéticos y la aparición de esta enfermedad. Esta área de investigación es vital para la medicina personalizada y la oncología pediátrica.
El profundo estudio del perfil epidemiológico puede brindar pistas fundamentales para la detección temprana y la mejora de los índices de supervivencia, que hoy día alcanzan aproximadamente un 90% en niños gracias a las mejoras en los esquemas terapéuticos. Para los especialistas, es imperativo mantenerse actualizado sobre estas tendencias y su impacto en la práctica clínica diaria.
4. Etiología y factores de riesgo de la leucemia linfocítica aguda
Los desórdenes genéticos tales como el síndrome de Down han demostrado incrementar la predisposición a desarrollar leucemia linfocítica aguda (LLA). Las anormalidades cromosómicas son hallazgos comunes, siendo translocaciones específicas como la t(12;21)(p13;q22), que resulta en el gen de fusión ETV6-RUNX1, indicativas de un subtipo de LLA con una respuesta favorable al tratamiento.
Otras alteraciones cromosómicas de importancia incluyen la hiperdiploidía, la cual suele presentar un pronóstico más favorable, y la t(9;22)(q34;q11.2), conocida como el cromosoma Filadelfia, la cual se asocia a un pronóstico adverso. El conocimiento detallado de la biología molecular subyacente de la LLA es esencial para un enfoque terapéutico dirigido y personalizado.
La exposición a radiaciones ionizantes ha sido identificada como un factor de riesgo significativo para la LLA. Aunque un evento agudo de radiación es raro, los sobrevivientes de catástrofes nucleares, como los observados en Hiroshima y Chernobyl, han demostrado una incidencia aumentada de leucemias. La exposición profesional o médica a la radiación también debe ser considerada dentro del análisis de riesgo en la anamnesis del paciente.
Los factores ambientales, como la exposición a ciertos químicos, incluyendo benceno y algunos pesticidas, han sido vinculados al desarrollo de LLA. Además, la hipótesis de la "higiene", que sugiere que la falta de exposición a infecciones durante la primera infancia conduce a una respuesta inmunitaria alterada, podría contribuir al aumento en la susceptibilidad a la LLA.
Es crítico considerar la exposición ambiental prolongada y los antecedentes de respuesta inmunológica anómala en el historial clínico del paciente, lo cual podría ofrecer pistas fundamentales para la estrategia diagnóstica y terapéutica.
5. Fisiopatología de la leucemia linfocítica aguda
La leucemia linfocítica aguda (LLA) es una neoplasia hematológica caracterizada por la proliferación descontrolada de linfoblastos inmaduros en la médula ósea y otros órganos hematopoyéticos. Estas células progenitoras se acumulan y pueden invadir espacios extramedulares, lo que provoca una falla medular por la sustitución del tejido hematopoyético normal.
Desde una perspectiva molecular, la LLA se asocia con numerosas anomalías genéticas que incluyen translocaciones, hiperdiploidías, hipodiploidías y mutaciones puntuales, cada una alterando el curso normal de la diferenciación y proliferación linfocítica. Esas alteraciones llevan al bloqueo de la diferenciación y a la resistencia a la muerte celular programada, aspectos fundamentales en la fisiopatología de la LLA.
La invasión de los linfoblastos a sistemas como el nervioso central y el esquelético provoca un conjunto diverso de síntomas clínicos que pueden incluir dolor óseo, linfoadenopatías, hepatosplenomegalia y manifestaciones meníngeas. La compresión de órganos o vasos por la masa tumoral puede resultar en síndromes específicos, como la compresión de la vena cava superior o el síndrome de lisis tumoral durante el tratamiento.
El microambiente medular también juega un papel crucial en la fisiopatología de la LLA, donde células estromales, citocinas y factores de crecimiento pueden promover la supervivencia de las células leucémicas y mediar en su resistencia a los tratamientos. La investigación actual se enfoca en identificar blancos moleculares específicos que puedan ser utilizados para desarrollar terapias dirigidas y mejorar así el pronóstico de los pacientes con LLA.
5.1. Avances recientes en el entendimiento de la LLA
Los recientes avances en la biología molecular y genética han permitido un mejor entendimiento de las bases de la LLA. Esto se refleja en la identificación de subtipos moleculares de la enfermedad que tienen diferentes implicaciones pronósticas y terapéuticas. La clasificación de la LLA en base a estas características ha permitido estratificar a los pacientes y personalizar los regímenes de tratamiento.
Además, las terapias dirigidas y la inmunoterapia ofrecen ahora opciones de tratamiento prometedoras que se suman a los enfoques tradicionales. Técnicas como la edición de genomas y el uso de anticuerpos monoclonales específicos han mostrado resultados alentadores en estudios clínicos, abriendo nuevas rutas en la lucha contra la LLA.
Cabe destacar, finalmente, que cualquier nuevo tratamiento ha de considerar la heterogeneidad y la complejidad biológica de la LLA, enfocando no solo en las células tumorales, sino también en su interacción con el entorno medular y el sistema inmunitario del paciente.
6. Presentación clínica de la leucemia linfocítica aguda
La leucemia linfocítica aguda (LLA) es una enfermedad hematológica caracterizada por la proliferación incontrolada de linfoblastos en la médula ósea y otros tejidos. Los especialistas deben estar atentos a su presentación clínica diversa, que a menudo incluye síntomas inespecíficos y signos que pueden pasar desapercibidos en las fases iniciales.
Entre los hallazgos más comunes se encuentran las manifestaciones de anemia, como la palidez, fatiga y disnea de esfuerzo. La trombocitopenia suele ocasionar hematomas fácilmente, petequias y, ocasionalmente, sangrados severos. La afectación del sistema inmunitario puede resultar en una susceptibilidad incrementada para infecciones, mientras que la infiltración del sistema nervioso central puede causar cefalea y vómitos.
Es vital también reconocer las adenopatías, hepatoesplenomegalia y dolor óseo como signos de alerta ante la posibilidad de LLA. La detección temprana es crucial para el pronóstico del paciente, por lo que un alto índice de sospecha clínica es indispensable frente a este panorama sintomático.

7. Diagnóstico de la leucemia linfocítica aguda
Métodos diagnósticos iniciales
El proceso diagnóstico de la leucemia linfocítica aguda (LLA) en médicos especialistas comienza con una anamnesis detallada y un examen físico exhaustivo. Signos como adenopatías, esplenomegalia o signos de sangrado pueden ser indicativos. La confirmación diagnóstica se inicia con un hemograma completo que revela una anemia normocítica normocrómica, trombocitopenia y variaciones en la cuenta de leucocitos. La presencia de blastos en sangre periférica es altamente sugestiva de LLA.
La biopsia de médula ósea y el aspirado medular son pruebas cruciales que no solo confirman la presencia de blastos linfoides, sino que también permiten la evaluación de la morfología celular y los patrones de crecimiento.
Pruebas citogenéticas y Moleculares
Las pruebas citogenéticas como el cariotipo analizan las alteraciones cromosómicas específicas de las células blásticas, las cuales pueden tener implicaciones pronósticas significativas. FISH (Hibridación Fluorescente In Situ) y la PCR (Reacción en Cadena de la Polimerasa) detectan alteraciones moleculares y translocaciones específicas, como el cromosoma Filadelfia.
La inmunofenotipificación por citometría de flujo es una herramienta indispensable que permite caracterizar la población blástica, diferenciando entre LLA de linaje B o T. Estos datos son esenciales para el diseño del plan terapéutico específico para cada paciente.
Importancia de la valoración integral
La integración de la historia clínica, hallazgos físicos y datos de laboratorio es esencial para un diagnóstico temprano y preciso. Los especialistas deben considerar las presentaciones atípicas y la posibilidad de diagnósticos diferenciales. Una vez establecido el diagnóstico, es fundamental iniciar rápidamente el tratamiento adecuado y realizar un seguimiento estrecho del estado del paciente, monitoreando la respuesta a la terapia y la aparición de posibles complicaciones.
8. Estudios de laboratorio en el diagnóstico de la leucemia linfocítica aguda
El diagnóstico de la leucemia linfocítica aguda (LLA) requiere un análisis exhaustivo de los estudios de laboratorio. Estas pruebas son cruciales para identificar las características hematológicas específicas y las anomalías cromosómicas asociadas con esta enfermedad, lo cual es fundamental para desarrollar una estrategia de tratamiento efectiva. Los especialistas necesitan interpretar los resultados con precisión, considerando las variaciones que pueden presentar en función del subtipo de LLA y de las características individuales de cada paciente.
Dentro de los estudios de laboratorio primordiales, encontramos el hemograma completo, la citometría de flujo, el análisis molecular y el estudio citogenético. Cada uno de estos aporta información valiosa para un diagnóstico certero y la posterior toma de decisiones clínicas. A continuación, presentamos una tabla comparativa que resume los hallazgos claves en cada estudio y su relevancia en el diagnóstico de la LLA.
Estudio
Hemograma Completo
Citometría de Flujo
Análisis Molecular
Estudio Citogenético
Hallazgos clave
Anemia, trombocitopenia, leucocitos variables con presencia de blastos.
Identificación de poblaciones anormales de células B o T precursoras.
Detección de alteraciones genéticas, translocaciones, y mutaciones específicas.
Cariotipo anormal, presencia de translocaciones y otros cambios cromosómicos.
Relevancia diagnóstica
Indica alteraciones en la producción de células sanguíneas y posible infiltración de la médula ósea.
Permite la clasificación inmunofenotípica de la LLA.
Define el pronóstico y facilita el seguimiento de la respuesta al tratamiento.
Ayuda a identificar subtipos específicos de LLA y sus implicaciones pronósticas.
La interpretación de estos estudios requiere de un conocimiento profundo de la hematología y la oncología. Por ejemplo, el hallazgo de una translocación t(9;22) en el estudio citogenético, conocida como el cromosoma Filadelfia, está asociado con un peor pronóstico y exige un manejo terapéutico específico. De igual manera, una elevada carga de enfermedad mínima residual detectada mediante análisis molecular después del tratamiento inicial indica la necesidad de terapias adicionales para prevenir la recurrencia de la enfermedad.
9. Estudios de imagen en el diagnóstico de la leucemia linfocítica aguda

Resonancia magnética cerebral
La resonancia magnética (RM) cerebral es una herramienta avanzada en la detección de alteraciones intracraneales asociadas a la leucemia linfocítica aguda (LLA). La capacidad de la RM para brindar imágenes detalladas de estructuras blandas resulta esencial para identificar la posible infiltración leucémica en el sistema nervioso central (SNC), un paso crítico para planificar un abordaje terapéutico adecuado para estos pacientes.

Tomografía computarizada de tórax
La tomografía computarizada (TC) de tórax permite la evaluación de complicaciones pulmonares en pacientes con LLA. Especificidades como infiltrados pulmonares o la presencia de masas mediastínicas pueden ser indicativos de enfermedad agresiva o complicaciones infecciosas. Por lo tanto, la TC es un componente indispensable del arsenal diagnóstico, proporcionando información valiosa para el manejo integral del paciente.

Ecografía doppler de órganos abdominales
La ecografía Doppler es otro método de imagen no invasivo, esencial para la evaluación de la arquitectura y la vascularización de los órganos abdominales en pacientes con LLA. Este procedimiento es significativamente útil para detectar esplenomegalia, hepatomegalia y alteraciones en los órganos que podrían sugerir infiltración leucémica o complicaciones secundarias a la enfermedad o su tratamiento.
10. Clasificación y estadificación de la leucemia linfocítica aguda
Clasificación inmunofenotípica
La leucemia linfocítica aguda (LLA) puede clasificarse según el linaje de las células leucémicas, así como su inmunofenotipo. La LLA de linaje B se caracteriza por el origen de células B precursoras y posee marcadores inmunológicos específicos como CD10, CD19 y CD20. La LLA de linaje T, en cambio, presenta células T precursoras con marcadores como CD2, CD3, CD7 y CD8. Esta diferenciación es crucial pues guía el tratamiento y tiene implicancias pronósticas marcadas, con la LLA de linaje B generalmente mostrando una respuesta al tratamiento más favorable.
Clasificación genética
Las alteraciones genéticas desempeñan un papel significativo en la patogenia de la LLA y sirven para profundizar en la clasificación de la enfermedad. Las anomalías cromosómicas, como la translocación t(9;22)(q34;q11.2) que produce el cromosoma Filadelfia, o las hiperdiploidías y hipodiploidías, son eventos claves en la oncogénesis y ofrecen información pronóstica esencial. Las mutaciones en genes como TP53 o IKZF1 también han sido asociadas con peores desenlaces, y su detección incide directamente en la toma de decisiones terapéuticas.
Estadificación clínica
La estadificación de la LLA no sigue el sistema tradicional TNM utilizado en otros cánceres, dado que la enfermedad se considera sistémica desde el diagnóstico. En su lugar, la evaluación se enfoca en la presencia de enfermedad mínima residual (EMR) post-tratamiento, que ha demostrado ser un fuerte marcador pronóstico. La cuantificación de EMR emplea técnicas avanzadas como la citometría de flujo y la PCR cuantitativa para detectar la persistencia de células leucémicas a niveles ínfimos, permitiendo adaptar la intensidad del tratamiento y monitorear la respuesta de cada paciente de manera individualizada.
11. Tratamiento de inducción en la leucemia linfocítica aguda
Antes de iniciar el tratamiento de inducción, es esencial realizar una evaluación clínica y de laboratorio exhaustiva del paciente. Esto incluye el estudio de las características citogenéticas y moleculares del blasto leucémico, las cuales pueden influir significativamente en la selección de la terapia y en las estrategias terapéuticas a largo plazo. La individualización del tratamiento según estos marcadores es un pilar fundamental para optimizar las posibilidades de remisión completa.
El régimen de tratamiento de inducción en la leucemia linfocítica aguda típicamente incorpora una combinación de quimioterapia con múltiples agentes. Los protocolos más comunes suelen incluir un antraciclina como la daunorrubicina o la doxorrubicina, junto con vincristina, corticoesteroides como la prednisona o dexametasona, y la L-asparaginasa. La elección y dosificación de estos fármacos son determinadas cuidadosamente en función del perfil de riesgo y la tolerancia del paciente.
El seguimiento durante la inducción implica una vigilancia estrecha de los posibles efectos secundarios y complicaciones. Se presta especial atención a las infecciones oportunista, la toxicidad de órganos, y la neuropatía periférica, implementando medidas de soporte adecuadas y ajustes en la quimioterapia según sea necesario. La profilaxis de la enfermedad del injerto contra el huésped y la gestión de la citopenia son igualmente críticas para mantener la calidad de vida del paciente y maximizar las posibilidades de éxito del tratamiento.
12. Tratamiento de consolidación en la leucemia linfocítica aguda
La fase de consolidación en la leucemia linfocítica aguda (LLA) es un segmento crítico del abordaje terapéutico integral en pacientes que han alcanzado la remisión completa tras la inducción. Esta etapa busca erradicar las células leucémicas residuales y prevenir recaídas, lo que se logra mediante la intensificación del tratamiento.
Las estrategias para la fase de consolidación varían dependiendo del perfil de riesgo del individuo y de la respuesta al tratamiento inicial. Por lo general, la consolidación incluye una combinación de fármacos quimioterapéuticos administrados en ciclos que buscan destruir las células leucémicas que no fueron eliminadas en la inducción. Este tratamiento intensivo puede ir seguido por un trasplante de células madre en ciertos casos, particularmente en aquellos pacientes con un alto riesgo de recurrencia de la enfermedad.
Es imperativo que los planes de tratamiento se personalicen para reflejar las necesidades específicas del paciente, considerando tanto la efectividad potencial de los tratamientos como los efectos secundarios asociados. La supervisión constante mediante pruebas de laboratorio y evaluaciones médicas regulares es fundamental durante esta fase para monitorear la respuesta al tratamiento y ajustar la terapia según sea necesario.
13. Tratamiento de mantenimiento en la leucemia linfocítica aguda
El tratamiento de mantenimiento para la leucemia linfocítica aguda (LLA) es una fase crucial que sigue a la remisión inducida por la terapia de inducción. Su objetivo es eliminar cualquier célula leucémica residual y prevenir la recurrencia de la enfermedad. Este tratamiento es prolongado y menos intensivo, pero esencial para lograr una cura a largo plazo.
Quimioterapia oral
Administración diaria de agentes como la mercaptopurina.
Corticoesteroides
Uso pulsátil de dexametasona o prednisona para reducir la inflamación y la actividad leucémica.
Terapia intratecal
Aplicación de quimioterapia directamente en el líquido cefalorraquídeo para tratar o prevenir la infiltración meníngea.
Mantenimiento del soporte vital
Acompañamiento con transfusiones y antimicrobianos preventivos.
Es imperativo un monitoreo hematológico frecuente durante esta fase para ajustar las dosis de las drogas y manejar los efectos secundarios. El tratamiento de mantenimiento puede durar varios años y su éxito depende de la adherencia del paciente y la vigilancia del equipo médico especializado.
14. Tratamiento de recaída en la leucemia linfocítica aguda
El abordaje terapéutico frente a la recaída de la leucemia linfocítica aguda (LLA) en pacientes requiere una estrategia meticulosamente planificada y altamente especializada. La recurrencia de la LLA es un escenario desafiante y a menudo sugiere un pronóstico reservado, dado que el arsenal terapéutico puede verse limitado por la exposición previa a tratamientos intensivos.
La reinducción con quimioterapia sigue siendo el pilar en el tratamiento de recaída, ajustando los esquemas a la tolerancia previa y respuesta del paciente. La inclusión de nuevos agentes inmunoterapéuticos y el uso de terapia dirigida, según el perfil molecular de la enfermedad, han mostrado ser herramientas valiosas que pueden incrementar la tasa de remisión y ofrecer un puente hacia un trasplante de células hematopoyéticas, cuando sea factible.
Las opciones de tratamiento son personalizadas, teniendo en cuenta aspectos como la duración de la remisión previa, las características cytogenéticas de la leucemia, la edad y condición general del paciente, entre otros. El trasplante sigue representando la esperanza de una cura definitiva para muchos pacientes, aunque los riesgos asociados deben ser sopesados cuidadosamente junto con el paciente y su familia.
15. Trasplante de células madre en la leucemia linfocítica aguda
Evaluación del paciente
Antes de proceder con un trasplante de células madre, es imperativo realizar una evaluación exhaustiva del paciente. Esta evaluación debe incluir un análisis detallado de la historial médico, la etapa de la leucemia y la respuesta previa a tratamientos. Los especialistas deben considerar la carga tumoral y las condiciones clínicas del paciente para estimar las posibilidades de éxito del trasplante.
Selección del donante
La selección de un donante compatible es un paso crítico en el proceso del trasplante de células madre. Se deben realizar pruebas de histocompatibilidad para asegurar la compatibilidad del HLA. Una correspondencia de HLA idéntica entre el donante y el receptor puede reducir significativamente el riesgo de enfermedad injerto contra huésped, una complicación potencialmente mortal.
Extracción y manipulación de células
La extracción de células madre del donante requiere procedimientos especializados que pueden incluir la movilización y la aféresis. Posteriormente, las células madre pueden ser manipuladas en el laboratorio para aumentar la eficacia del trasplante, como la eliminación de células T o el trasplante de células madre amplificadas en número. La tecnología de punta en hematología permite perfeccionar estas técnicas para obtener resultados más favorables.
Protocolo del trasplante y Seguimiento
El procedimiento del trasplante mismo implica protocolos rigurosamente establecidos para la infusión de células madre en el receptor. Posteriormente, el seguimiento clínico es esencial para evaluar el injerto, la reconstitución inmunitaria y la aparición de complicaciones. Los médicos deben estar preparados para intervenir con medidas de soporte vital y terapia contra complicaciones como la enfermedad injerto contra huésped y las infecciones oportunistas.
16. Terapias dirigidas en la leucemia linfocítica aguda
Las terapias dirigidas han representado un avance significativo en el tratamiento de la leucemia linfocítica aguda (LLA), ofreciendo opciones más precisas y menos tóxicas que las terapias convencionales. Estos tratamientos son diseñados para identificar y atacar características específicas de las células cancerosas, lo que permite un abordaje más enfocado. La inclusión de terapias dirigidas en el manejo de la LLA ha contribuido a mejorar las tasas de remisión y la calidad de vida de los pacientes.
Es importante que, como médicos especialistas, estemos al tanto de los índices de eficacia y las estadísticas relacionadas con estas terapias novedosas. A continuación, se presentan cifras relevantes que destacan la importancia y la eficacia de las terapias dirigidas en la LLA.
5YR
Sobrevivencia
La tasa de supervivencia a 5 años para pacientes bajo terapias dirigidas ha visto un incremento, reflejando la eficacia a largo plazo de estos tratamientos.
80%
Remisión
Una alta proporción de pacientes alcanza remisión completa con terapias dirigidas, demostrando ser una opción terapéutica poderosa frente a la enfermedad.
25%
Mínima residual
Reducción significativa en la enfermedad mínima residual, un marcador importante para la predicción de recaídas y resultado final del tratamiento.
40%
Recaída
La disminución de tasas de recaída en pacientes tratados con terapias dirigidas, resaltando la mejora en el control de la enfermedad a largo plazo.
17. Pronóstico y factores de riesgo en la leucemia linfocítica aguda
La evaluación del pronóstico y la identificación de los factores de riesgo constituyen un pilar fundamental en el tratamiento de la leucemia linfocítica aguda (LLA). A través de una comprensión detallada de las características intrínsecas de la enfermedad y la respuesta del paciente a la terapia, los hemato-oncólogos pueden adaptar los tratamientos para mejorar las tasas de supervivencia y calidad de vida.
Entre los factores de riesgo que afectan el pronóstico de la LLA, se encuentran la edad al diagnóstico, el recuento de leucocitos en sangre periférica, las anomalías citogenéticas, y la presencia de ciertas fusiones genéticas. Por ejemplo, pacientes menores de 35 años suelen tener un pronóstico más favorable, mientras que aquéllos con altos conteos de leucocitos o alteraciones genéticas como la t(9;22) enfrentan desafíos más significativos.
Además, la respuesta rápida al tratamiento inicial se correlaciona con un mejor resultado. Es esencial para el especialista determinar la presencia del "mínimo residuo enfermedad" post-tratamiento, ya que su detección precoz puede llevar a la modificación de la terapia para evitar recaídas. La precisión en el diagnóstico y en la aplicación de protocolos terapéuticos adaptativos influye enormemente en la progresión de esta enfermedad hemato-oncológica.
La investigación constante y la integración de nuevos conocimientos biomédicos también desempeñan un rol crucial en el manejo personalizado y en el impulso hacia el aumento de las tasas de remisión. Estudios en farmacogenómica y terapias dirigidas se abren paso prometiendo mejorar la estratificación de riesgo y las intervenciones terapéuticas. La LLA no sólo es un desafío clínico, sino también una invitación a la comunidad médica para no cesar en la búsqueda de respuestas más precisas y esperanzadoras.
18. Complicaciones y efectos secundarios del tratamiento en la leucemia linfocítica aguda
El tratamiento de la leucemia linfocítica aguda (LLA) ha avanzado significativamente, mejorando las tasas de supervivencia. Sin embargo, es importante que los médicos especialistas estén atentos a las posibles complicaciones y efectos secundarios que pueden surgir a lo largo del tratamiento. Estos efectos adversos pueden variar desde leves hasta potencialmente mortales, y su manejo adecuado es fundamental para garantizar la calidad de vida del paciente.
Uno de los efectos más conocidos es la mielosupresión, consecuencia de la quimioterapia. Esta condición se caracteriza por una producción reducida de células sanguíneas, lo que aumenta el riesgo de infecciones, anemia y sangrados. Asimismo, pueden presentarse náuseas, vómitos y mucositis como consecuencia directa del tratamiento citotóxico. Estos síntomas requieren un manejo específico y oportuno para evitar complicaciones como la deshidratación y la pérdida de peso.
Los especialistas también deben estar vigilantes ante la aparición de la neuropatía periférica, una complicación que puede llevar a la pérdida de sensibilidad en extremidades y dificultar la realización de actividades cotidianas. En ciertos casos, esta puede ser irreversible y mermar significativamente la calidad de vida del paciente. Del mismo modo, los efectos psicológicos del diagnóstico y tratamiento, como la depresión o la ansiedad, no deben subestimarse y requieren seguimiento por parte de un equipo multidisciplinario.
Finalmente, dado el uso de potentes agentes quimioterapéuticos, existe un riesgo no despreciable de desarrollar segundos cánceres como leucemias mieloides agudas y síndromes mielodisplásicos, especialmente en tratamientos que involucran agentes alquilantes o radioterapia. La prevención, detección precoz y el tratamiento de estas neoplasias secundarias son esenciales para mejorar la sobrevida a largo plazo de los pacientes con LLA.
18.1. Supervisión continua es clave para el éxito del tratamiento
El monitoreo cuidadoso de los signos vitales, las pruebas de laboratorio y las evaluaciones físicas periódicas son aspectos críticos en la identificación temprana de estos efectos secundarios. Una comunicación efectiva entre el paciente y el equipo médico también es vital para ajustar las terapias y manejar las complicaciones de la manera más eficiente posible. Los especialistas deben, por tanto, mantenerse actualizados sobre las mejores prácticas y protocolos de tratamiento para minimizar el impacto adverso de las terapias y maximizar la recuperación y el bienestar de los pacientes.
Es indispensable recordar que el tratamiento de la LLA es un proceso complejo que requiere una perspectiva integral y personalizada para cada paciente. La ciencia médica continúa avanzando y, con ella, las estrategias para mitigar las adversidades asociadas al tratamiento de esta grave enfermedad.
19. Seguimiento y cuidados a largo plazo en la leucemia linfocítica aguda
La importancia del seguimiento tras el tratamiento de la leucemia linfocítica aguda (LLA) es crucial para detectar precozmente cualquier signo de recurrencia y abordar los efectos tardíos del tratamiento. Las estrategias de seguimiento incluyen exámenes físicos regulares, análisis de sangre periódicos y, en ciertos intervalos, estudios de imagen para evaluar el estado de remisión. Los protocolos de seguimiento pueden variar según los factores de riesgo y la respuesta previa al tratamiento. Además, se debe prestar especial atención a la monitorización de la función cardíaca y pulmonar, particularmente en pacientes que han recibido antraciclinas o radioterapia.
Es fundamental que los especialistas involucrados en este proceso mantengan un enfoque multidisciplinario para ofrecer una atención integral al paciente, incluyendo apoyo psicológico, nutricional y, en caso de necesidad, rehabilitación física. La comunicación constante entre oncólogos, hematólogos, médicos de atención primaria y otros profesionales de la salud es vital para un seguimiento efectivo.
El manejo de las complicaciones tardías en pacientes con LLA es un componente esencial en la atención de seguimiento. Esto incluye identificar y tratar secuelas hematológicas tales como la disfunción de médula ósea, así como complicaciones derivadas de la quimioterapia o la radioterapia. Algunas de estas pueden ser endocrinológicas, como hipotiroidismo o insuficiencia suprarrenal, o musculoesqueléticas como osteonecrosis. La detección temprana de otros tipos de cáncer secundarios, particularmente aquellos relacionados con la exposición a radiación o agentes alquilantes, es fundamental para iniciar tratamientos oportunos.
El soporte a largo plazo también incluye el asesoramiento sobre estilos de vida saludables para mitigar riesgos adicionales, la vacunación según las directrices actuales, y la evaluación del funcionamiento cognitivo y social para promover una calidad de vida óptima. Profesionales especializados en oncohematología pediátrica o en el seguimiento de sobrevivientes de cáncer pueden brindar una guía invaluable en estas áreas.
Es conveniente que los pacientes sean incorporados en programas de seguimiento a largo plazo específicamente diseñados para sobrevivientes de LLA, donde puedan recibir una evaluación especializada de forma periódica.
20. Avances y nuevas investigaciones en la leucemia linfocítica aguda
La comunidad científica está haciendo avances prometedores en la lucha contra la leucemia linfocítica aguda (LLA). Enfocados en ampliar las opciones terapéuticas y mejorar el pronóstico de los pacientes, los especialistas combinan conocimientos de genética, farmacología y biología molecular en su búsqueda por soluciones efectivas.
Terapias dirigidas: La identificación de características moleculares específicas de las células leucémicas ha permitido la creación de medicamentos que se dirigen a estas anomalías. Los inhibidores de tirosina quinasa, por ejemplo, han mostrado beneficios significativos en pacientes con mutaciones particulares, ofreciendo un tratamiento más personalizado y con menos efectos secundarios.
Inmunoterapia: Las terapias inmunitarias, incluyendo el uso de células T con receptores de antígeno quimérico (CAR-T), están revolucionando el tratamiento de la LLA resistente o recidivante. Este enfoque reprograma las células T del paciente para que reconozcan y destruyan células leucémicas, con tasas de remisión completa que alcanzan y a veces superan el 70% en poblaciones específicas.
Terapia genética: La edición de genes, utilizando herramientas como CRISPR-Cas9, se explora como una técnica para corregir mutaciones genéticas causantes de la enfermedad o para modificar células inmunitarias del paciente, mejorando su capacidad para luchar contra el cáncer.
Mejora del trasplante de células hematopoyéticas: El refinamiento de los protocolos de trasplante y la mejora en la compatibilidad de tejidos amplían las posibilidades exitosas de esta opción terapéutica, disminuyendo la incidencia de rechazo y enfermedad injerto contra huésped.
Agentes pro-apoptóticos: Investigaciones recientes en agentes que promueven la apoptosis, o muerte celular programada, en células leucémicas podrían proporcionar una estrategia eficaz para eliminar células cancerígenas sin afectar a las células normales.
Estas líneas de investigación ilustran el compromiso de la medicina con el avance continuo y la esperanza de ofrecer a los pacientes con LLA tratamientos más efectivos y menos tóxicos en el futuro próximo.
21. Recursos y apoyo para pacientes con leucemia linfocítica aguda
Educación y formación continua
La necesidad de una educación constante sobre la leucemia linfocítica aguda (LLA) es imperativa para los médicos especialistas, ya que permite un diagnóstico más temprano y un tratamiento más efectivo. Se sugiere el acceso a publicaciones médicas actuales y a cursos de capacitación en hemato-oncología que incluyan avances en la biología molecular de la LLA y nuevas terapias dirigidas.
Estos recursos educativos deben ser precisos y provenientes de instituciones de renombre en el campo de la hematología, para garantizar que la información sea de alta calidad y basada en evidencia científica actualizada.
Soporte multidisciplinario
La gestión de la LLA requiere un enfoque multidisciplinario que implica a oncólogos, hematólogos, enfermeros especializados, psicólogos, y trabajadores sociales. Los especialistas deben promover y facilitar grupos de soporte para pacientes y sus familias, ofreciendo un espacio para compartir experiencias y manejar la carga emocional que implica la enfermedad.
El apoyo incluye asesoramiento sobre opciones de tratamiento, efectos secundarios, y estrategias de afrontamiento, así como orientación sobre recursos financieros y legales disponibles para los pacientes.
Avances tecnológicos y de investigación
Es crucial mantenerse actualizado sobre las innovaciones tecnológicas y los avances investigativos en la lucha contra la LLA. Esto abarca desde las nuevas modalidades de terapia genética y celular, como la CAR-T, hasta las últimas investigaciones en farmacogenómica para personalizar los planes de tratamiento.
Los médicos deben tener acceso a bases de datos de estudios clínicos y resultados de investigaciones recientes para aplicar los conocimientos a la práctica clínica y contribuir al progreso terapéutico en la leucemia linfocítica aguda.
22. Casos clínicos y experiencias de médicos especialistas en leucemia linfocítica aguda
El análisis comparativo de casos clínicos provee una herramienta invaluable para los especialistas en el campo de la hematología. Es a través de la meticulosa revisión de experiencias pasadas y la valoración de las diversas aproximaciones terapéuticas, que los médicos pueden afinar sus estrategias y ofrecer a sus pacientes una atención personalizada y efectiva.
En este espacio reunimos una serie de casos clínicos documentados por especialistas en leucemia linfocítica aguda (LLA), con el propósito de compartir conocimientos que contribuyan a mejorar las prácticas médicas y, en consecuencia, los resultados en el manejo de esta enfermedad.
Estos ejemplos reflejan la complejidad en el manejo de la leucemia linfocítica aguda y la importancia de abordajes interdisciplinarios que consideren las características individuales de cada paciente. La colaboración entre instituciones y la actualización constante en las metodologías de tratamiento son cruciales para el avance en la lucha contra esta forma de cáncer sanguíneo.
23. Preguntas frecuentes sobre la leucemia linfocítica aguda
Morfología celular distintiva
En la leucemia linfocítica aguda (LLA), la observación microscópica de las células es crucial. El diagnóstico se basa en la identificación de las células blásticas caracterizadas por sus núcleos grandes y heterocromatina dispersa. Comprender la morfología de estas células permite a los médicos especialistas reconocer variantes de la enfermedad y estructurar un plan terapéutico individualizado.

Equipo médico multidisciplinario
El tratamiento de la LLA requiere un enfoque integrado. Los equipos multidisciplinarios están compuestos por especialistas en hemato-oncología, enfermería oncológica, trabajadores sociales y más, quienes colaboran para diseñar un protocolo terapéutico óptimo, manejar los efectos secundarios y proporcionar apoyo psicológico al paciente durante este proceso arduo.

Avances en quimioterapia
La LLA es una enfermedad que ha visto un progreso significativo en su tratamiento gracias a la quimioterapia. La optimización de regímenes de fármacos y el seguimiento personalizado de los pacientes han mejorado las tasas de remisión. Los especialistas se mantienen al tanto de novedades terapéuticas, lo que incluye el uso de quimioterapia dirigida que ataca células específicas y reduce el daño a tejidos sanos.
24. Referencias bibliográficas y fuentes consultadas
Bases de datos biomédicas
Para la consolidación de este apartado se han consultado diversas bases de datos de renombre internacional como PubMed, Medline y Scopus, donde se han seleccionado publicaciones científicas que abordan los aspectos más actuales y críticos en el estudio y tratamiento de la leucemia linfocítica aguda (LLA). Se ha priorizado el acceso a artículos de revisión sistemática y meta-análisis que ofrecen una visión integradora y evaluación de los resultados clínicos obtenidos.
Monografías especializadas y capítulos de libro
Se han revisado monografías y capítulos de libros enfocados en hematología y oncología pediátrica, con un énfasis particular en las neoplasias hematológicas. Dichas fuentes permiten una comprensión detallada de la patogénesis, las manifestaciones clínicas y las estrategias terapéuticas frente a la LLA. En particular, se ha hecho uso de las obras editadas o escritas por figuras de autoridad en el campo, como "Hematology: Basic Principles and Practice".
Guías de práctica clínica y consensos
Las recomendaciones de tratamiento se han basado en guías de prácticas clínicas y documentos de consenso de sociedades científicas relevantes, como la Sociedad Americana de Hematología (ASH) y la Asociación Europea de Hematología (EHA). Estas guías ofrecen pautas basadas en la evidencia y son fundamentales para estandarizar la atención de pacientes con LLA, promoviendo la adopción de las mejores estrategias diagnósticas y terapéuticas disponibles.
Conferencias y simposios especializados
Para mantener actualizado el contenido de esta sección, se ha hecho seguimiento de las ponencias y avances presentados en conferencias y simposios internacionales, como el Congreso Anual de la ASH y reuniones de la European Hematology Association. Estos eventos son el escenario donde expertos en la materia presentan y discuten los avances más recientes en investigación y tratamiento de la LLA, lo que permite la incorporación de datos y perspectivas de vanguardia en nuestra presentación.
25. Aviso legal y política de privacidad
Marco legal
El aviso legal y la política de privacidad constituyen elementos esenciales en la gestión de la información en entornos digitales. Estos documentos están arraigados en la legislación vigente para garantizar la transparencia y el respeto a la privacidad del usuario. La normativa aplicable incluye, pero no se limita a, el Reglamento General de Protección de Datos (RGPD) de la Unión Europea, y la Ley Federal de Protección de Datos Personales en Posesión de los Particulares en el caso de México.
Responsabilidades del proveedor
En el aviso legal, se establecen las responsabilidades del proveedor de servicios, delineando el alcance de su oferta y los términos del servicio prestado. Detalla las condiciones de uso, los derechos de propiedad intelectual y establece las limitaciones de responsabilidad. Es crucial que los profesionales médicos y especialistas estén conscientes de estas regulaciones al ofrecer servicios o información a través de plataformas digitales, para proteger tanto su praxis como los derechos de sus usuarios.
Confidencialidad y seguridad de los datos
La política de privacidad es el documento donde se informa al usuario sobre el tratamiento de sus datos personales, especificando los datos que se recopilan, el fin de su tratamiento y cómo estos son protegidos. La encriptación de datos y el manejo confidencial son aspectos que reflejan el compromiso con la seguridad de la información. Los especialistas deben asegurarse de que las plataformas que utilizan para intercambiar información del paciente cumplan con estos estándares para mantener la integridad del manejo de datos médicos.
Obligaciones del usuario
Finalmente, es de vital importancia que los usuarios de plataformas digitales médicas comprendan sus obligaciones y el correcto uso de la información proporcionada. Esto incluye el compromiso de no difundir información confidencial y de adherirse a los términos de uso del servicio. La educación sobre estos temas es fundamental para evitar malentendidos y posibles brechas en la privacidad, asegurando así una relación de confianza entre el profesional y el paciente.

